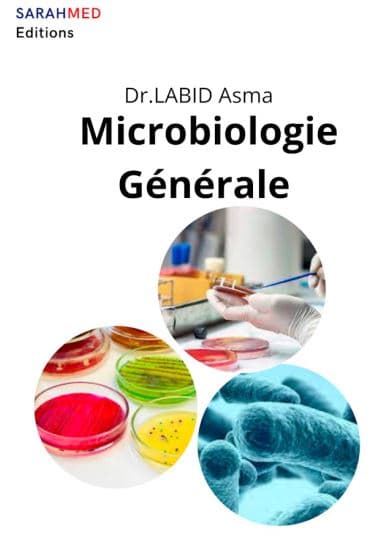
Couverture — Microbiologie générale

Publication vérifiée — éditée officiellement par SARAHMED Éditions
Microbiologie générale
Asma LABID
- Pages
- 128
- Type
- Livre
Résumé
"Microbiologie générale" est un livre complet et accessible pour les étudiants. Avec ses huit chapitres, il couvre les fondements de la microbiologie, en abordant des sujets tels que la classification bactérienne, la nutrition, la croissance et les agents antimicrobiens. Les chapitres sur la mycologie et la virologie fournissent également une introduction pratique aux autres domaines de la microbiologie. Les illustrations en couleurs et les diagrammes aident à clarifier les concepts clés et à renforcer la compréhension.